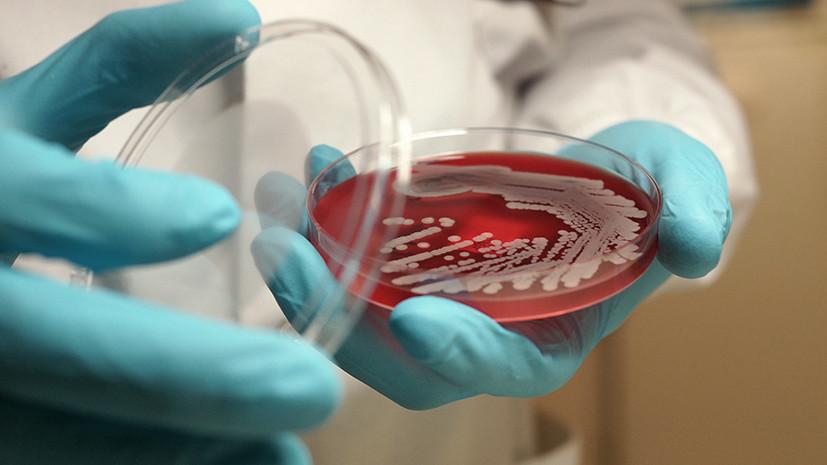

Сибирская язва новости украина
В Украине впервые за 4 года зафиксирован случай заражения человека сибирской язвой. Это опасное инфекционное заболевание, при легочной форме которого летальность достигает 100%, при кишечной - 50%, а при кожной - 10-20%. И хотя власти уверяют, что ситуация под контролем, утверждать, что опасность миновала, в ближайшие две недели, похоже, нельзя. Сибирская язва может стать очередным бичом после воскресших в Украине ботулизма, лептоспироза, бешенства и до сих пор не побежденной африканской чумы свиней



В Украине впервые за 4 года зафиксирован случай заражения человека сибирской язвой. Это опасное инфекционное заболевание, при легочной форме которого летальность достигает 100%, при кишечной - 50%, а при кожной - 10-20%. И хотя власти уверяют, что ситуация под контролем, утверждать, что опасность миновала, в ближайшие две недели, похоже, нельзя. Сибирская язва может стать очередным бичом после воскресших в Украине ботулизма, лептоспироза, бешенства и до сих пор не побежденной африканской чумы свиней
Центр общественного здоровья Минздрава подтвердил случай заболевания сибирской язвой у человека. Заболевший является одним из пяти человек, участвовавших в забое скота в селе Меняйловка Одесской области. Несмотря на то, что у остальных четверых сибирскую язву пока не подтвердили, сообщается, что они были "госпитализированы со специфическими симптомами заболевания кожи". При кожной форме заболевания сибирской язвой, как правило, через два-три дня после заражения у человека появляется красноватое пятнышко, которое превращается в пузырек. Затем пузырек лопается, и на его месте появляется язва с черным дном. Вокруг струпа вскоре возникают новые пузырьки, и в итоге образуется струп-карбункул (некротическое воспаление глубоких слоев кожи). В области язвы отсутствует чувствительность, ткани вокруг нее отекают. Симптомами заболевания также является повышение температуры тела до 38-40 градусов, сильная головная боль, общее недомогание, карбункулы с быстрым нарастанием отека и ощущениями зуда, сильная колющая боль в груди (в случае легочной формы), удушье, диарея с примесью крови (в случае кишечной формы), а также режущие боли в животе, рвота с примесью крови.
Новости по теме
Новости по теме
У заболевшего в Одесской области подтверждена кожная форма сибирской язвы. В МОЗ утверждают, что она лечится антибиотиками и не представляет такой опасности, как легочная форма. Известно, что при легочной форме сибирской язвы летальность достигает 100%, при кишечной - 50%, а при кожной только 10-20%. В то же время вследствие любого из способов заражения может развиться сепсис (заражение крови), уточняют в Центре общественного здоровья МОЗ.
В МОЗ утверждают, что нынешняя вспышка сибирской язвы в Одесской области локализована и угрозы распространения инфекции нет. В то же время исключать, что число заболевших может увеличиться, пока нельзя. "Медики будут наблюдать за состоянием здоровья жителей села на протяжении 15 дней: ежедневно осуществляются обходы домовладений для контроля состояния здоровья людей, которые потенциально могут заразиться возбудителем. Лицам, которые имеют риск заражения, будут назначать срочную профилактику антибиотиками", - говорится в сообщении Центра общественного здоровья. Средняя продолжительность инкубационного периода заболевания составляет от 2-3 до 8-14 суток.
Новости по теме
Новости по теме
Человек заражается от больного травоядного животного через поврежденную (даже микротравмой) кожу или слизистые оболочки во время обработки туш, через контакт с грунтом, зараженным спорами сибирской язвы (во время выполнения земляных работ). Кроме того, путем приготовления и употребления еды из мяса, полученного от больных животных. Сибирская язва передается путем вдыхания ее спор, а также через укус насекомых (комаров, мух, оводов). При этом от человека к человеку (контактным путем) заболевание не передается.
Чтобы понять, насколько живучим является возбудитель и как молниеносно он может распространяться, достаточно знать, что он относится к третьей группе биологической опасности и в некоторых странах (в частности, КНДР) изучался как эффективное биологическое оружие. Заведующая кафедрой инфекционных болезней в Национальном медицинском университете им. А.А. Богомольца Ольга Голубовская утверждает, что возбудитель сибирской язвы есть на вооружении минимум 5 стран (в том числе и штаммы, которые резистентны к антибиотикам). Эксперты ВОЗ подсчитали, что через 3 дня после распыления 50 кг спор над двухкилометровой зоной по направлению ветра в сторону города с населением 500 тыс. человек будет наблюдаться инфицирование 125 тыс. (25%) жителей и 95 тыс. (!) летальных исходов.
Новости по теме
Новости по теме
В частности, история знает случай "лихорадки почтового терроризма" в США в 2001-2002 годах. Ее причиной был порошок, содержащий споры сибирской язвы. Из-за него заболели 22 человека, а пятеро погибли. Ещё раньше, в 1979 году, в закрытом от мира СССР произошёл, пожалуй, крупнейший инцидент, связанный с массовым заражением сибиреязвенными бациллами в небоевых условиях. Тогда в Свердловске, по официальным данным, погибли 64 человека, по неофициальным - тысячи.
В селе Меняйловка, как официально установлено, причиной заражения стала инфицированная корова. Исследование мяса забитого животного и грунта во дворе (от 2 октября) дало позитивный результат. Как правило, животные, которые становятся источником заражения человека, могут заболеть, съев траву на зараженном пастбище или попив воды из инфицированного водоема. Споры "сибирки" могут сохраняться в грунте около 70 лет и активизироваться, когда его поверхность нарушается, например, в результате наводнения или смещения. В Госпродпотребслужбе не исключают, что возможным источником заболевания стали споры, которые находились в почве после случая сибирской язвы, который был зафиксирован в расположенном недалеко от Меняйловки селе в 1999 году.
Новости по теме
Новости по теме
Сейчас в Меняйловке и на прилегающей территории пастбища (90 га) установлен карантин: запрещена реализация сельскохозяйственных животных и продуктов животного происхождения, которых содержат в селе и выпасали на пастбище (непосредственно на пастбище проводится дезинфекция). Также запрещен сбор и прием молока, полученного от коров из Меняйловки. На въездах и выездах из села установлено 6 полицейских постов. Кроме того, признаны зоной угрозы территории Петропавловского, Фараоновского и Старосельского сельсоветов.
Главное управление Госпродпотребслужбы в Одесской области полностью обеспечено вакцинами против сибирской язвы животных и дезинфекторами для обеспечения мероприятий по локализации и ликвидации болезни, сообщили в пресс-службе Госпродпотребслужбы. Также уточнили, что в связи со случаем заболевания "проведено дополнительное вакцинирование животных, привиты 204 головы КРС и 1 тыс. овец из села Меняйловка".
На вопрос о том, как вышло так, что заболевшее животное (если других случаев заболевания в ближайшие две недели не будет) оказалось непривитым и почему это никто не проконтролировал, якобы должна дать ответ Нацполиция. "Направлено обращение в Главное управление Нацполиции в Одесской области в отношении открытия уголовного производства в соответствии со статьей 251 Уголовного кодекса – несоблюдение ветеринарных правил, что привело к нарушению эпизоотии или к другим тяжелым последствиям".
Новости по теме
Новости по теме
Впрочем, с учетом того, что до сих пор нет информации о доведении до логического завершения хотя бы одного расследования, связанного со вспышками таких опасных заболеваний, как лептоспироз, бешенство, ботулизм, надежды на то, что это дело закончится чем-то, кроме тягомотины и отписки, нет. Отметим, что до сих пор не известно о наказании виновных во вспышке опаснейшего заболевания, которым несколько лет охвачена Украина, – африканской чумы свиней (до 2012 года в Украине не фиксировалась). Заболевание стало причиной гибели сотен тысяч животных, разорения ферм, резкого роста цен на свинину из-за дефицита. Согласно подсчетам Ассоциации "Свиноводы Украины", только в 2016 году африканская чума свиней нанесла 4,81 млн долл. убытков.
Победить эпидемию АЧС не удалось до сих пор, и сообщения о вспышках то и дело поступают из разных областей. Недавно вспыхнул скандал в Херсонской области, где из-за бешенства и вспышки АЧС уже сожгли пять с половиной тысяч свиней. Чтобы не допустить дальнейшего распространения эпидемии, местные власти приняли решение гуманными методами уничтожить бродячих собак и кошек, которые могут быть потенциальными разносчиками заболеваний. После значительного общественного резонанса и обращения зоозащитников 28 сентября на заседании Государственной чрезвычайной эпизоотической комиссии при Херсонском горсовете было принято решение воздержаться от уничтожения бездомных животных. В Госпродпотребслужбе уточнили: "Вместо этого принято решение об отлове бездомных животных на определенной территории и содержании их в вольерах с целью наблюдения, стерилизации, учета, идентификации и вакцинации".

Украинские СМИ утром второго октября сообщили о госпитализации пяти человек из села Меняйловка Одесской области с симптомами, похожими на сибирскую язву. Началось все с одного двора, в котором хозяйка заметила нетипичное поведение у коровы и поняла, что животное заболело.
Пять человек госпитализировали на Украине с подозрением на сибирскую язву
По ее мнению, четверо мужчин и женщина, которые пришли резать корову, наверняка имели ранки на коже. Именно кожная форма сибирской язвы и была позднее подтверждена у одного из пяти госпитализированных, участвовавших в забое больного скота.
В официальном сообщении Минздрава Украины говорится, что ситуация под контролем, за состоянием здоровья живущих в селе людей будут наблюдать в течение 15 дней, а госпитализированные — на лечении.

Источник фото: бацилла сибирской язвы
По сообщению СМИ, на подъезде к Меняйловке поставили шесть блокпостов полиции, въезд в село закрыт. Выезжающих проверяют на наличие мяса — его вывозить запрещено. Местные жители опасаются, что из-за вспышки инфекции придется резать всю скотину. Врачи успокаивают тем, что от человека к человеку болезнь не передается.
После сообщения о ситуации в Одесской области местные СМИ стали выяснять, готовы ли ведомства и государство в случае эпидемии защитить народ и какими средствами. В Минздраве Украины после того, как рассказали о состоянии здоровья госпитализированных с подозрением на сибирскую язву и подробно изучили памятку о заболевании, заявили, что государство вакцину не закупает.
Он добавил, что прививки в частном порядке могут делать работодатели сотрудникам тех специальностей, которые имеют повышенный риск заражения сибирской язвой, например, пастухи, мясники, обвальщики мяса на мясокомбинатах.
Курпита добавил, что инфицированное мясо — основной источник заражения людей сибирской язвой. Животные через траву, произрастающую на пораженной почве, могут стать невольными распространителями болезни.
В самом же Минздраве заявили лишь о вспышках заболевания, которые возникают время от времени при контакте человека с заболевшим животным:
2003 год — Харьковская область — 1 случай;
2004 год — Черновицкая область — 3 случая;
2008 год — Николаевская область — 1 случай;
2012 год — Черкасская область — 1 случай.
Курпита подчеркнул, что при всех зарегистрированных эпизодах смертельных случаев среди людей не было.
Возбудителем сибирской язвы является бактерия Bacillus anthracis. Бациллу сибирской язвы как причину болезни впервые обнаружил Роберт Кох в 1875 году. А 2 июня 1881 года Луи Пастер представил миру первую вакцину.
Бациллы сибирской язвы — одни из самых устойчивых к переменам внешних условий среды: могут сохраняться в почве десятки лет, даже в условиях вечной мерзлоты, устойчивы к экстремально высоким температурам — их гибель не гарантируют даже 20 минут кипячения.
Вдохновит Аль Пачино: глава Минздрава Украины призвала заняться танцами
Споры бактерий, ввиду исключительной живучести и сохранности, способны провоцировать новые вспышки заболевания в местах, где земляной покров (льды) повреждены погодными явлениями (дожди, селевые сходы, таяние). Произрастающая на зараженной почве трава или вода, протекающая по земле со спорами пробудившегося вируса, становится причиной болезни домашнего скота и заражает людей.
Человек может заразиться сибирской язвой только при непосредственном контакте с больным животным. В зоне риска люди, которые работают со скотом и на мясопроизводстве: с костями, шерстью, кожей, мясом. Заражение происходит при микротравмах кожи или слизистых оболочек во время ухода за больными животными, обработке мяса и шкур, приготовлении и употреблении мяса больных животных, при вдыхании спор вируса или укусе зараженных насекомых (мух, комаров, слепней).
От человека к человеку вирус не передается.

Источник фото: pxhere.com
Известно три вида сибирской язвы, разнящихся симптомами: кожная, легочная и кишечная. Инкубационный период заболевания 2-3 дня (колебания составляют от нескольких часов до 8-14 суток).
— Второй признак: высокая температура, выше 39 градусов, под 40, слабость.
— Третьим признаком является кишечное расстройство (понос, рвота).
В Минздраве Украины в перечне симптомов заболевания сибирской язвой упоминаются также сильная головная боль, сильные колющие боли в груди и удушье (при легочной форме), диарея и рвота с примесью крови, режущие боли в животе (при кишечной форме).
По мнению медиков, все формы заболевания при своевременном диагностировании и обращении к врачу лечатся антибиотиками. По данным доктора Александра Мясникова, на 96 заболевших сибирской язвой приходится один летальный исход.
На территории России крупнейшая вспышка сибирской язвы была зафиксирована в советском Свердловске (ныне Екатеринбурге) весной 1979 года. Из 96 заболевших тогда людей погибли две трети (64 человека).

Вакцина против сибирской язвы поступит в охваченную карантином Туву
К ликвидации последствий вспышки вируса привлекли более 200 военнослужащих, 19 единиц спецтехники, передвижные лаборатории, четыре вертолета Ми-8, беспилотники, а также 50 специалистов и 13 единиц спецтехники подразделений радиационной, химической и биологической защиты.
Он добавил, что оленеводство не самый прибыльный вид бизнеса, и на первом этапе с вакцинацией оленеводам могло бы помочь государство. Он также добавил, что на территории России зарегистрировано более 100 тысяч сибиреязвенных скотомогильников. Около 400 из них расположены в Арктическом регионе, где все чаще потепление приводит к таянию льдов и вечной мерзлоты.

В Одесской области подтвердилась вспышка страшного смертельного заболевания - сибирской язвы. В пределах всего села Меняйловка введен карантин.
Сибирской язвой заражаются люди, которые контактируют с продуктами животного происхождения, а также их жизнедеятельности. Инфицироваться можно через кожу, а в редких случаях - через слизистые оболочки дыхательных путей или ЖКТ. Все, что нужно знать об опасной болезни, - в материале OBOZREVATEL.
В основном сибирской язве подвержен крупный рогатый скот, а также козы, овцы и лошади. В развитых странах мира распространение естественной инфекции значительно сократилось. Кроме того, благодаря профилактике на промышленных производствах продуктов животного происхождения и в сельских хозяйствах – люди стали заражаться реже.
Кроме смертельного исхода и страшного течения болезни, человечество пугает еще и то, что споры сибирской язвы применяются в качестве биологического оружия. Факт биотерроризма, к примеру, был зарегистрирован в 2001 году в США, когда споры переработанные до вида мелкой пудры распространялись через почтовую службу.
Споры сибирской язвы чрезмерно "живучие". Они могут десятилетиями оставаться активными. Когда они попадают в богатую почву – кровь или ткани, – то начинают размножаться.
Кожная – развивается вследствие контакта с инфицированным животными или продуктами животного происхождения. Опасность заключается еще и в том, что эта форма может передаваться контактно-бытовым путем от человека к человеку. Именно эта форма сибирской язвы вспыхнула в Одесской области.
ЖКТ- не передается от человека к человеку. Возможно заражение из-за употребления в пищу мясных продуктов, которые не прошли достаточную термическую обработку. При такой форме заболевания у человека формируются некротические язвы от ротовой полости до слепой кишки. Возможны кровоизлияния и даже перфорация тканей.
Аспираторная (легочная форма) - не передается от человека к человеку. Вызывается вдыханием спор, скорее связанна с профессиональной деятельностью и чаще других заканчивается летальным исходом.
увеличение местных лимфоузлов;
тошнота и рвота;
красно-коричневые папулы, которые вызывают зуд, обычно, проявляются в течении 1-10 дней после инфицирования;
прогрессирует до язвы в центре папулы;
черная корочка на язве.
рвота и тошнота;
возможна брюшная водянка.
по первым симптомам похожа на грипп;
с каждым днем температура поднимается все выше;
возможно появление синюшной окраски кожи и слизистых;
Если вовремя не обратиться за помощью, вероятность смерти достаточно высока, хотя и зависит от формы заболевания. К примеру, выживаемость при кожной форме - 80-90%, если вовремя обратиться в медучреждение. Сибирская язва ЖКТ без необходимого лечения заканчивается летально в 50% случаев, а легочная - в 100%.
О лечении и профилактике рассказал OBOZREVATEL, врач-эксперт Виктор Литвиненко:
"Пациентов с сибирской язвой определяют в инфекционный стационар. Важно понимать, что чем раньше человек получит необходимое лечение, тем больше вероятность выжить.
Обычно больным прописывают комплексное лечение, в которое входит: постельный режим, терапия антибиотиками пенициллинового ряда и фторхинолоны на протяжении 1-2 недель, введение готовых антител против сибирской язвы. Для кожной формы также используется местное лечение в виде антисептиков и стерильных повязок, которые накладываются на язвы. Чтобы снять интоксикацию, в тяжелых случаях, больным добавляют Преднизолон. Выписывают пациентов лишь получив отрицательные результаты бактериологического исследования и после полного отторжения струпа, если речь идет о кожной форме заболевания.
Важно понимать, что этим недугом возможно заразиться повторно, поскольку после перенесенного заболевания пожизненного иммунитета не появляется. Для безопасности населения проводится профилактика против сибирской язвы, которой должны заниматься ветеринарные службы. Они выявляют заболевание у животных и сжигают зараженное поголовье. Инфицированные пастбища с отходами жизнедеятельности зараженных животных на многие годы изолируются.
Эффективной в борьбе с распространением сибирской язвы является вакцинация поголовья скота, а также людей, которые находятся в группе риска: ветеринаров, военных, служащих в лабораториях, где занимаются изучением сибирской язвы, работников мясокомбинатов и промышленной переработки продуктов животного происхождения.



Сибирская язва - острое инфекционное заболевание, возбудителем которой является споровидная бактерия Bacillus anthracis. Это острая инфекционная болезнь животных и человека, имеющего преимущественно кожную форму, реже - легочную и кишечную формы с явлениями сепсиса.
Распространенность
Сибирская язва присутствует в большинстве частей мира, но частота вспышек варьируется.
Споры бактерий сибирской язвы могут оставаться в латентном состоянии в почве длительное время и активизироваться, когда поверхность почвы нарушается, например, в результате наводнения, ливня или оползней. Заболевание, как правило, появляется снова, когда споры попадают в желудок животного с травой на пастбищах.
Сегодня заболеваемость носит спорадический характер - проявляется только иногда и отдельными вспышками.
Источники заражения и пути передачи
Эта инфекция относится к зоонозов - то есть человек инфицируется или от зараженного животного, или от контакта с кожей и шерстью.
Основной источник инфекции - больные домашние травоядные животные: крупный и мелкий рогатый скот. Животные заражаются, съев траву, другие корма или выпив зараженной воды.
Сибирской язвой чаще болеют люди, которые работают с животными и животными продуктами - костями, шерстью, кожей, мясом.
Сибирская язва не передается от человека к человеку.
Пути передачи инфекции:
- контактный - через поврежденную (даже микротравмами) кожу или слизистые оболочки при уходе за больными животными; во время обработки туш, снятия шкуры и захоронение трупов погибших животных; с зараженным спорами сибирской язвы почвой во время земляных работ;
- алиментарный - через приготовления и употребления пищи из мяса, полученного от больных животных;
- аэрогенный (воздушно-пылевой) - путем ингаляции спор;
- трансмиссивный - через укусы насекомых (слепней, мух, комаров).
Симптомы сибирской язвы
Средняя продолжительность инкубационного периода заболевания - 2-3 дня, возможны колебания от нескольких часов до 8-14 суток.
В организм инфекция попадает через кожу, слизистые оболочки верхних дыхательных путей, реже - слизистые оболочки кишечника. Поэтому существует три формы сибирской язвы: кожная, легочная, кишечная.
Заболевание начинается остро: в первые часы - температура тела резко повышается до 38-40 ° С и возникает слабость. Заражение крови (сепсис) может развиться вследствие любого способа заражения.
Признаки сибирской язвы:
- сильная головная боль4
- высокая температура,
- общее недомогание;
- карбункул с быстрым нарастанием отека и зуд (по поражения кожи);
- сильные колющие боли в груди (в случае легочной формы);
- удушье (при легочной формы);
- диарея с примесью крови (при кишечной формы);
- режущие боли в животе (в случае кишечной формы);
- рвота с примесью крови (при кишечной формы).
Если лечение начинается вовремя, больные выздоравливают. В редких случаях течение болезни осложняется кишечной, легочной или септической формами. Заболевание имеет тяжелое течение и может привести к смерти больного.
При малейшем подозрении на сибирскую язву нужно обращаться к врачу!
Лечение сибирской язвы
Лечение проводят только в условиях стационара. Возбудители сибирской язвы чувствительны к антибиотикам. Не пытайтесь применять антибиотики или любые другие препараты для самолечения или профилактики без консультации врача.
При малейшем подозрении на любую форму заражения требуется немедленная госпитализация!
Советы по профилактике инфицирования сибирской язвой
- покупайте мясо и мясопродукты лишь в местах, где качество продуктов контролируют;
- люди, которые перерабатывают и реализуют мясо, мясопродукты или любую животноводческую сырье, обязаны соблюдать гигиенические нормы, чтобы обезопасить себя и других;
- выполнения ветеринарно-санитарных правил при уходе за животными;
- убой домашнего скота только с разрешения ветработников;
- упорядоченное захоронения трупов животных;
- ветеринарный контроль меховой и кожаной сырья;
- контроль заболеваемости животных;
- уничтожение зараженных трупов животных;
- прививки животных против сибирской язвы;
- получения лицами, имевшими контакт с больными животными или сырьем от больных животных, экстренной профилактики антибиотиками
Ранее летом 2017 года Государственная служба по вопросам безопасности пищевых продуктов и защиты потребителей обнаружила в Сумской области захоронение 2 трупов овец, зараженных сибирской язвой.
В селе Николаевка-Новороссийская Одесской области введён двухнедельный карантин. Специалисты подозревают, что одна из коров пала от сибирской язвы. При этом в начале октября вспышка смертельно опасного заболевания была зарегистрирована в другом населённом пункте этого же района. Опрошенные RT эксперты отмечают, что эпидемии на Украине происходят всё чаще, поскольку система здравоохранения переживает глубочайший кризис, сообщает RT.
В Саратском районе Одесской области введён 14-дневный карантин, сообщили RT в Одесской областной государственной администрации. Решение было принято после того, как в ветеринарную службу поступила информация о смерти одной из коров в частном подворье села Николаевка-Новороссийская.
По словам собеседника RT, в этом селе, согласно плану-графику вакцинации, было привито 110 голов крупного рогатого скота, однако 12 октября поступило сообщение о падеже шестилетней коровы с симптоматикой, очень схожей с заболеванием сибирской язвой.
Во время карантина ветеринары должны будут обойти все дома в селе Николаевка-Новороссийская и вакцинировать животных. Людям, которые с ними контактируют, медицинские работники должны рассказать об особенностях течения болезни и убедить при малейших признаках заболевания обращаться к врачу, добавил собеседник RT. Кроме того, на период действия карантина местным жителям запрещено продавать сельскохозяйственную продукцию.
По его словам, сибирская язва — устойчивое во внешней среде и очень опасное заболевание, его возбудитель может сохранять свою жизнеспособность десятилетиями. Эпидемиолог предупреждает, что сейчас в зоне риска оказалось огромное количество людей — работники ферм, пищевых предприятий и те, кто занимается первичной обработкой мяса.

При этом поставить правильный диагноз на ранней стадии довольно сложно, поскольку симптомы сибирской язвы совпадают с симптомами гриппа или ОРВИ: у больного повышается температура, появляется озноб и увеличиваются лимфоузлы.
По его словам, заболевание может осложняться распадом тканей, нарушением работы кровеносной системы, сепсисом, токсическим шоком от распада клеток, отёком лёгких и удушьем. Также заболевание может привести и к поражению головного мозга.
Первый случай заболевания сибирской язвой был зафиксирован в начале октября этого года в другом населённом пункте Саратского района Одесской области — селе Меняйловка. Тогда с подозрением на сибирскую язву были госпитализированы пять человек. Как выяснилось позже, все они употребляли в пищу мясо одной и той же коровы.

Спустя три дня новый случай заболевания был зафиксирован в другой части страны — в Житомирской области. В больницу попала 35-летняя женщина из села Белка Коростенского района Житомирской области с подозрением на кожную форму сибирской язвы.
По его словам, уже не один месяц Украине не удаётся побороть эпидемию кори, гепатита С, туберкулёза. На подходе эпидемия дифтерии, а теперь и сибирская язва.
По данным Министерства здравоохранения Украины, за одну прошлую неделю в стране заболели корью 707 человек — 189 взрослых и 518 детей. Это на 28% больше, чем на предыдущей неделе. С начала года эту болезнь зафиксировали у 33,2 тыс. человек.

А источник в Министерстве здравоохранения сообщил RT, что ведомство регулярно обращается за помощью к различным международным организациям, которые помогают обеспечивать страну вакцинами.
Украина не может справиться с этой проблемой самостоятельно, а странам ЕС невыгодно заниматься меценатством, рассказал в интервью RT заведующий кафедрой политологии и социологии РЭУ им. Г.В. Плеханова Андрей Кошкин.

Киев, 29 октября.
Жителям Незалежной не позавидуешь. Специалисты бьют тревогу - в стране сплошь и рядом фиксируются факты заболевания корью, сибирской язвой и гриппом среди жителей Украины. А эти болезни при несвоевременном лечении могут привести к серьезным последствиям и даже смерти.
Грипп - лечение и профилактика
На шутки нет времени. Октябрь в 2018 году действительно оказался весьма теплым, но, несмотря на хорошую погоду, за одну неделю более 153 тысяч украинцев заболели гриппом и ОРВИ, из них 70,1% - дети в возрасте до 17 лет. Среди взрослого населения уровень заболеваемости вырос на 6,5%, а среди детского - на 14%!
По данным Министерства здравоохранения, в прошлом эпидсезоне умерли семь человек от гриппа, ни один из этих пациентов не был от него привит. Поэтому, чтобы не подцепить вирус, нужно делать прививки. За прошлую неделю против гриппа вакцинирован всего 421 человек (по всей стране!), из них 74,6% - лица из групп риска.

Всего в 2018 году корью заболели 33165 человек - 13184 взрослых и 19981 ребенок. Только с 1 по 7 октября 2018 года на Украине зарегистрировано 554 случая заболевания корью, из которых 397 среди детей. С начала года от осложнений после кори умерли 14 человек, 10 из которых дети.

По мнению специалистов, сложившееся неблагополучие в стране наблюдается из-за ситуации, при которой детские дошкольные учреждения и школы посещает значительное количество невакцинированных детей, что создает дополнительные риски для новых вспышек. Уже известно что из-за вспышки кори в Ивано-Франковской области были закрыты три школы. Еще одну школу закрыли в Черновицкой области.
Сибирская язва
На Украине уже зафиксированы случаи такой несвойственной для этой местной болезни, как сибирская язва. Первый случай заболевания был зафиксирован в начале октября этого года в населенном пункте Саратского района Одесской области — селе Меняйловка. Тогда с подозрением на сибирскую язву были госпитализированы пять человек. Как выяснилось позже, все они употребляли в пищу мясо одной и той же коровы.
Спустя три дня новый случай заболевания был зафиксирован в другой части страны — в Житомирской области. В больницу попала 35-летняя женщина из села Белка с подозрением на кожную форму сибирской язвы. В селе Николаевка-Новороссийская Одесской области введен двухнедельный карантин из-за опасного заболевания. Там люди не пострадали. Как отмечают эксперты, более 13,5 тыс. мест в стране могут представлять опасность заражения сибирской язвой.
По мнению специалистов, это одно из самых опасных заболеваний. Есть несколько форм: кожная, буллёзная, поражающая лимфатические узлы и поражающая внутренние органы. Смертность высокая. Главное не прозевать начало заболевания. Ведь от этого напрямую зависит летальность исхода. Вот только поставить правильный диагноз на ранней стадии довольно сложно, поскольку симптомы сибирской язвы совпадают с симптомами гриппа или ОРВИ: у больного повышается температура, появляется озноб и увеличиваются лимфоузлы.
Заболевание может осложняться распадом тканей, нарушением работы кровеносной системы, сепсисом, токсическим шоком от распада клеток, отёком лёгких и удушьем. Также заболевание может привести к поражению головного мозга. Лечение происходит исключительно в условиях стационара. Медики рекомендуют не применять антибиотики или любые другие препараты для самолечения или профилактики без консультации врача. При малейшем подозрении на любую форму заражения нужна немедленная госпитализация.
Тем временем, зная о росте количества больных гриппом, корью и даже сибирской язвой, глава МОЗ Украины Ульяна Супрун, вместо того, чтобы бить тревогу и принимать четкие и жесткие меры, попросту у себя в Facebook рекламирует программу "Доступные лекарства" и дает бесполезные советы.
Эксперты отмечают, что эпидемии на Украине происходят все чаще, поскольку система здравоохранения переживает глубочайший кризис. Если так пойдет и дальше, с таким подходом к вакцинации и лечению населения, не удивительно, если через год у нас появятся совершенно экзотические болезни, такие как малярия, холера или желтая лихорадка.
Читайте также:


